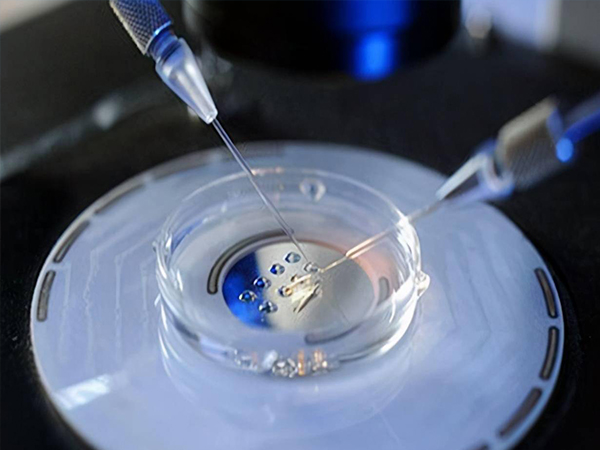

摘要
馬鞍山可以做試管嬰兒的醫院有馬鞍山市婦幼保健院。該院於2010年5月開始實施人類輔助生殖技術,成為本市唯一具備實施人類輔助生殖技術資質的中心。2012年,經原安徽省衛生廳批准開展產前診斷技術,填補了本市產前診斷和人類輔助生殖技術的空白。當然還可以選擇其他醫院進行試管嬰兒,但是選擇醫院時需要注意正規的醫院才是最放心的。試管嬰兒作為一種生殖技術,已經廣泛應用於臨床,技術發展良好。試管嬰兒技術正在被越來越多的人接受。試管嬰兒成功解決了長期困擾醫學界的不孕不育問題,給無數不孕不育家庭帶來了歡樂。而接下來是整理的一份關於馬鞍山試管嬰兒醫院大全,附選擇試管嬰兒醫院4要點供大家參考。

馬鞍山市婦幼保健院生殖醫學中心經原安徽省衛生廳批准,於2010年5月開始實施人類輔助生殖技術,成為本市唯一具備實施人類輔助生殖技術資質的中心。2012年,經原安徽省衛生廳批准開展產前診斷技術,填補了本市產前診斷和人類輔助生殖技術的空白。
2017年,經國家專家組批准,啟動體外受精-胚胎移植技術和卵胞漿內精子顯微注射(俗稱“試管嬰兒”)技術。也是安徽省地級市首家開展“試管嬰兒”技術的醫療機構。目前主要開展女性不育、男性不育、優生優育遺傳諮詢檢查等專案。
試管嬰兒成功率:33%-57%;試管嬰兒費用:3.5-8萬元。
醫療領域發展迅速,值得關注。也能給無法自然受孕的家庭很多幫助,讓家庭更加完整,帶來更多的支援和優勢。如今,試管嬰兒的出現給了很多家庭希望。在選擇醫院的時候,一定要注意是否有正規的營業執照和經過批准的許可證,這樣才能保證手術過程的順利和安全。

試管嬰兒的治療不同於一般的藥物治療。反覆去醫院需要幾個月甚至幾年,尤其是進入週期後的促排卵、取卵、移植等強化治療。根據試管嬰兒的醫學圖譜,選擇離家近的醫院,或者至少是離家交通方便的醫院,會為你以後的治療提供很多便利。
懷孕的夫婦,尤其是女方,需要去醫院十到幾十次。選擇一家讓自己舒服的醫院真的很重要。看看醫院的候診區和廁所,看你能不能受得了,因為你以後還得不停地和這種環境打交道。看醫院的醫囑,看準備懷孕的同志對所謂有經驗的人的評價,看試管嬰兒中心的流程設計是否方便簡化,這些都很重要。